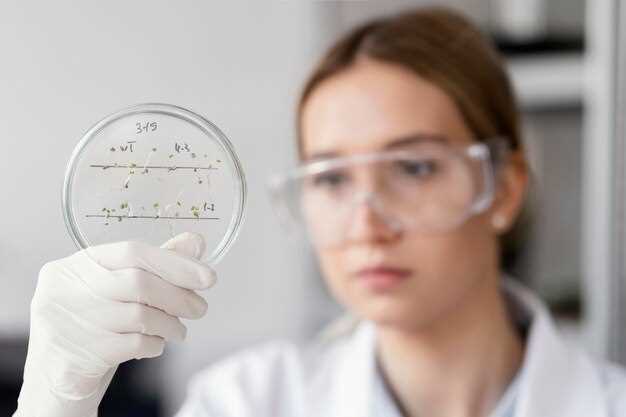

Исследования синаптической пластичности сосредоточены на понимании того, как нейронные связи изменяются под влиянием активности и опыта. Эти процессы играют решающую роль в обучении и формировании когнитивных функций, что делает их объектом активного изучения в нейронауке. Одним из ключевых аспектов является то, что изменения в синапсах могут значительно повлиять на способности мозга адаптироваться к новым условиям и обработке информации.
Современные нейробиологические исследования демонстрируют, что синаптическая пластичность может происходить в разных формах, таких как долговременная потенциация (ЛТП) и долговременная депрессия (ЛДП). Эти механизмы позволяют нейронам адаптироваться к изменениям в среде, что в свою очередь поддерживает обучение и запоминание. Научные исследования, проводимые в последние годы, акцентируют внимание на молекулярных и клеточных основах этих процессов, открывая новые горизонты в понимании работы мозга.
Влияние синаптической пластичности затрагивает не только память и обучение, но и регенерацию после травм. Связь между синаптическими изменениями и восстановлением нейронных сетей является важной темой для дальнейших исследований, что может привести к новым подходам в терапии нейродегенеративных заболеваний. Открытия в этой области актуальны не только для ученых, но также для практиков, работающих в области психологии и медицины.
Новые методы изучения синаптической пластичности в нейробиологии
Другим важным направлением является применение электроника на основе мягких материалов. Такие устройства могут интегрироваться в живую ткань без повреждения, обеспечивая мониторинг нейронной активности в реальном времени. Это помогает отслеживать, как изменения в нейронных соединениях коррелируют с поведением и когнитивными функциями животных.
Также используются методы визуализации, такие как флуоресцентная микроскопия с высоким разрешением, позволяющие зафиксировать динамику синаптических изменений на уровне отдельных нейронов. Эти технологии способствуют выявлению специфических молекулярных мишеней, ответственных за пластичность синапсов.
Кроме того, программные решения для моделирования нейронных сетей помогают исследователям предсказывать, как различные паттерны активации нейронов могут влиять на обучение и формирование памяти. Комбинация таких методов открывает новые горизонты для исследований мозга и углубляет понимание нейробиологии.
Синергия между экспериментальными и вычислительными подходами позволит более точно оценивать влияние синаптической пластичности на поведение, прокладывая путь к новым открытиям в нейронауке.
Влияние синаптической пластичности на обучение и память
Исследования показывают, что активация определенных путей в нейронных сетях влияет на скорость обучения. Так, синаптические изменения, вызванные повторяющейся активностью, приводят к укреплению синапсов, что называется долгосрочной потенциацией (ЛТП). Этот процесс лежит в основе формирования навыков и запоминания информации.
Кроме того, долговременная депрессия (ЛДП) отвечает за ослабление менее значительных связей, что позволяет оптимизировать нейронные сети для более эффективного хранения и извлечения информации. Нейробиология подчеркивает важность баланса между ЛТП и ЛДП в процессах обучения.
Изменения в синаптической активности также влияют на эмоциональные аспекты памяти. Например, эмоционально насыщенные события запоминаются лучше благодаря увеличенной синаптической пластичности в ответ на стрессовые факторы.
Продолжающиеся исследования в нейронауке стремятся лучше понять механизмы, связанные с изменениями в синапсах, что может привести к новым стратегиям для улучшения памяти и обучения. Технологические прогрессы, такие как оптогенетика, позволяют исследователям манипулировать синаптической активностью в живых нейронных сетях, что открывает новые горизонты в изучении регуляции обучения и памяти.
Нейронные сети и механизмы пластичности: последние достижения
Современные исследования подтверждают, что синаптическая пластичность играет ключевую роль в нейробиологических процессах обучения и памяти. Разработаны новые методы наблюдения за поведением синапсов, включая оптогенетику, что позволило исследовать механизмы пластичности мозга с высокой точностью.
Недавние открытия показывают, что изменения в структуре и функции синапсов могут быть связаны с когнитивными функциями. Взаимосвязь между нейронными сетями и синаптической пластичностью подтверждается данными о нейромодуляторах, которые регулируют процесс обучения, улучшая или подавляя передачу сигналов между нейронами.
Одним из наиболее замечательных достижений является идентификация молекулярных мишеней, ответственных за долговременную потенциацию, что открывает новые перспективы для лечения нейродегенеративных заболеваний. Эти результаты показывают, как глубокое понимание механизмов синаптической пластичности может привести к разработке новых терапий.
Исследования мозга, сосредоточенные на нейропластичности, указывают на то, что тренировка может вызывать изменения в синапсах, способствующие восстановлению утраченных функций после травм. Таким образом, знание о верхних механизмах может увеличить эффективность реабилитационных программ.
Научные исследования в области нейронауки продолжают выявлять сложные взаимосвязи между пластичностью мозга и его функциями. Эти достижения подчеркивают необходимость дальнейших исследований, которые смогут более глубоко понять, как взаимодействие макро- и микроструктур нейронных сетей влияет на поведение и восприятие.








